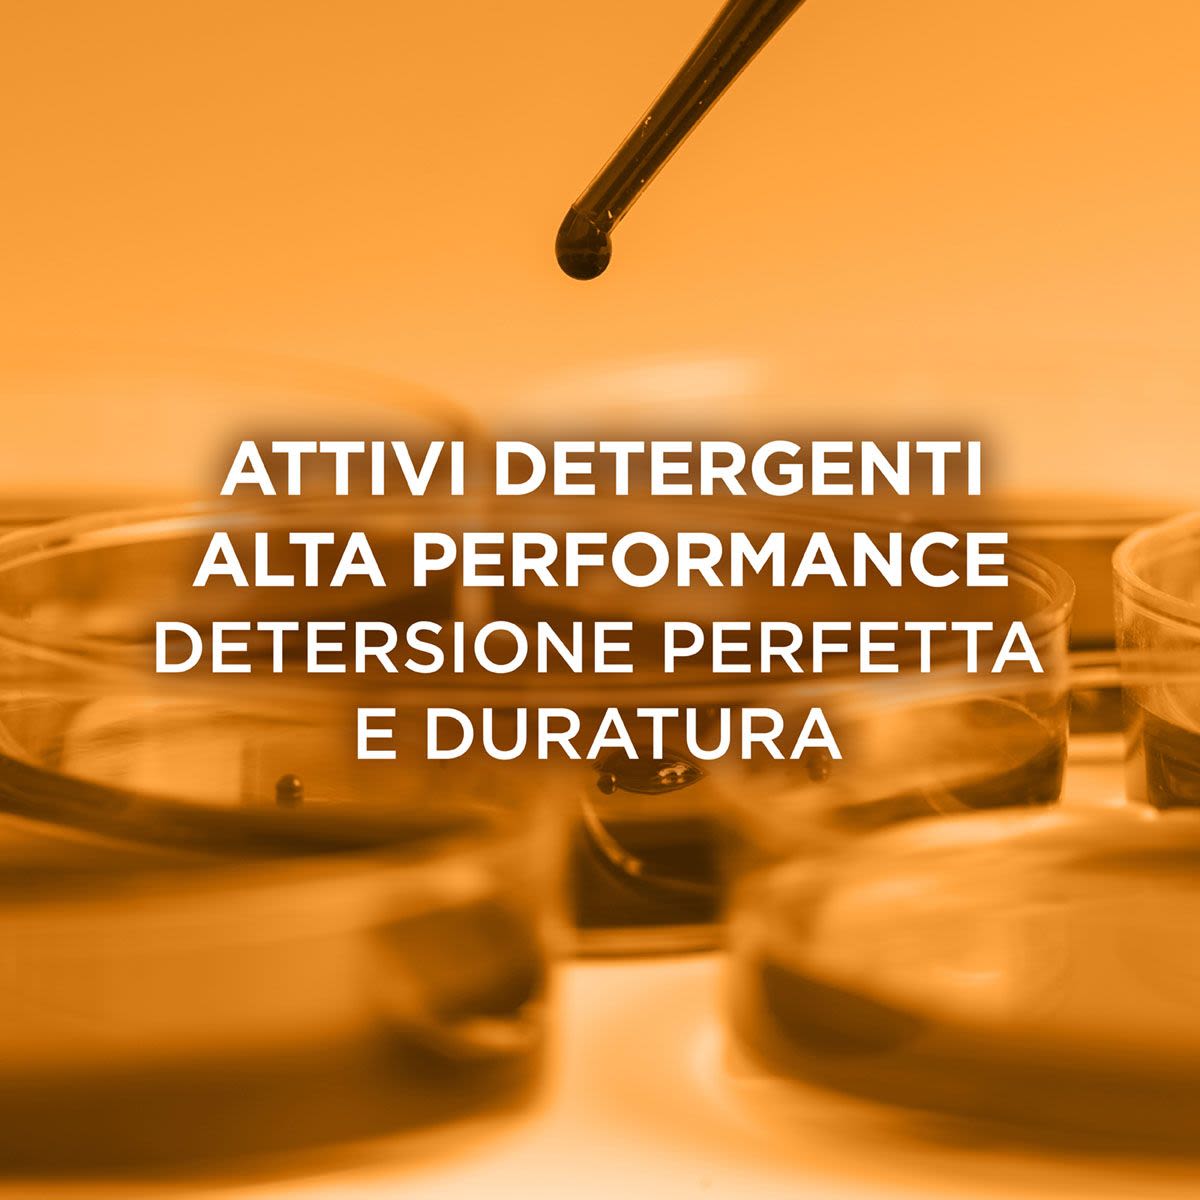
image - 982773018 - Elvive Piu Di Uno Shampoo Olio Straordinario capelli secchi 200ml - 4739012_4.jpg

Elvive Piu Di Uno Shampoo Olio Straordinario Capelli Secchi 200ml
Non disponibile
Ci dispiace, purtroppo questo prodotto non è disponibile.
Possiamo però consigliarti dei prodotti simili.
Elvive Piu Di Uno Shampoo Olio Straordinario capelli secchi 200ml
Elvive Piu Di Uno Shampoo Olio Straordinario capelli secchi 200ml è uno shampoo per capelli secchi nutriente.
Ingredienti
Aqua / Water, Sodium Laureth Sulfate, Cocamidopropyl Betaine, Cetearyl Alcohol, Ammonium Lauryl Sulfate, Parfum / Fragrance, Sodium Chloride, Bis(C13-15 Alkoxy) Pg-amodimethicone, Chamomilla Recutita Flower Extract / Matricaria Flower Extract, Cocos Nucifera Oil / Coconut Oil, Tocopherol, Sodium Benzoate, Hydroxypropyl Guar Hydroxypropyltrimonium Chloride, Peg-30 Dipolyhydroxystearate, Eugenol, Trideceth-6, Salicylic Acid, Polyquaternium-7, Dilauryl Thiodipropionate, Helianthus Annuus Seed Oil / Sunflower Seed Oil, Calendula Officinalis Flower Extract, Limonene, Linalool, Benzoic Acid, Benzyl Alcohol, Cinnamal, Linum Usitatissimum Flower Extract / Linseed Flower Extract, Alpha-isomethyl Ionone, Caprylyl Glycol, Caprylic/capric Triglyceride, Caprylic/capric Glycerides, Acrylates/c10-30 Alkyl Acrylate Crosspolymer, Gardenia Taitensis Flower, Rosa Canina Flower Extract, Citric Acid, Citronellol, Hexyl Cinnamal
*le Liste Degli Ingredienti Dei Prodotti Di L’oreal Paris Vengono Regolarmente Aggiornate. Ti Invitiamo Quindi A Leggere La Lista Che Trovi Sulla Confezione Del Prodotto Per Assicurarti Che Gli Ingredienti Siano Adatti Al Tuo Utilizzo Personale
Modo d' uso
Applica il prodotto sulle mani, crea la schiuma, massaggia delicatamente sulla cute e sulle lunghezze, infine risciacqua.
Formato
200 ml